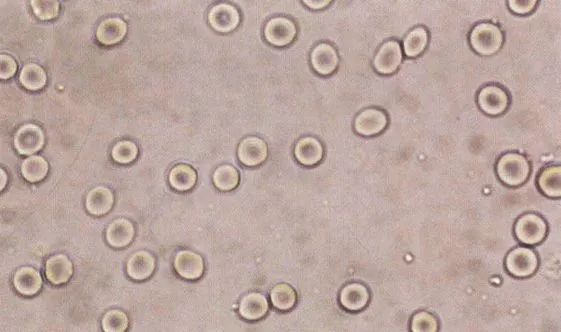

26岁的小王一大早就慌张地奔到医生面前:“医生,我可能出大事了!”
医生问:“你哪里不舒服?”
小王欲言又止,最后扭扭捏捏小声说,“早晨上厕所时,尿里有血……”
又忍不住紧跟一句:“医生,这严不严重啊?”

医生经过一番询问得知,原来小王前一晚逛超市,发现了红心火龙果打折,就买了很多。
回家后——都!吃!了!
好了破案了。
事实上,引起“血尿”甚至“血便”的原因很多,颜色也不一样。
有暂时性的,也有病理性的。
所以千万不要因为看见尿中带血,就惊慌失措!
● 剧烈运动、重体力劳动后、冷水洗澡,或站立时间过长,健康人可能出现暂时性血尿。
● 吃了某些带颜色的蔬菜水果,尿液也可能变红。
● 某些药物及其代谢产物,如利福平、苯妥英钠、酚噻嗪等,可能导致尿液变红(利福平是一种紫红色结晶状粉末;口服后可使尿液呈红色或橘红色。但此时尿常规检查可能没有发现红细胞)。
一般来说,在人群中,血尿的检出率从1%到18%不等。
这取决于患者的年龄、性别、检测频率和是否有上面这些情况[1-3]。
而病理性血尿原因很多,需要详细区分和鉴别。


一般来说,血尿分为“镜下血尿”和“肉眼血尿”。
正常人随机留的一次尿,在显微镜下很难直接看到红细胞。
而当尿液离心浓缩以后,在高倍镜视野下就能看见红细胞:
● 红细胞>3个时,称为“镜下血尿”。此时肉眼一般看不到尿液有明显血色。
● 当1L尿的含血量在1mL以上时,肉眼能观察到尿呈红色,医学上称之为“肉眼血尿”。

根据尿液中红细胞的形态,可以将血尿分为三种。
1. 均一性红细胞血尿
● 尿中红细胞>8000/mL,超过70%的红细胞外形及大小正常,红细胞膜完整,形态单一。
● 多为非肾小球源性血尿,多因毛细血管破裂引起[4]。
● 尿蛋白不会增多,或增加不明显。
长这样:
(来源:临床检验诊断学图谱)
2. 非均一性红细胞血尿(变形红细胞性血尿)
● 超过70%的红细胞有2种以上变形:①大小;②形态;③血红蛋白含量。
● 多为肾小球源性血尿[5]。
● 常伴有尿蛋白常增多[6]。
长这样:

(来源:临床检验诊断学图谱)
3. 混合性血尿
此时,尿中含有均一性和非均一性两类红细胞。

1. 均一性红细胞血尿:
1. 暂时性的镜下血尿:剧烈运动,长时间站立,冷水浴,重体力劳动。
2. 泌尿系统疾病:如泌尿系统炎症、结石、结核、肿瘤、肾移植排斥反应、先天性尿路畸形、外伤等。左肾静脉受压综合征,肾血管疾病,如肾静脉血栓、动静脉瘘等。药物导致肾及膀胱损伤,如环磷酰胺[7]。
3. 生殖系统疾病:如前列腺炎、精囊炎等。
4. 全身性疾病:感染性疾病;内分泌代谢疾病;血液病如血小板减低性紫癜、血友病;心血管疾病,结缔组织病。

(肾结石的类型)
2. 非均一性红细胞血尿:
常见于急性肾小球肾炎、慢性肾小球肾炎、肾盂肾炎、红斑狼疮性肾炎、肾病综合征等。
3. 混合性血尿
可能不止一个部位出血。不过常见原因是IgA肾病。

不同原因,常需要不同的检查。
当出现血尿、同时有不适症状时,可以去当地正规医院就诊,并进行相应检查。
常见的检查有如下几种:
1. 尿常规加沉渣镜检:
尿常规检测有无尿蛋白, 尿沉渣观察有无红细胞管型及颗粒管型、白细胞管型等。
2. 尿红细胞位相:
70%以上红细胞为异常形态(畸形或多型性)可确定为肾小球性血尿。
3. 尿三杯试验:
收集初、中、末段尿液进行肉眼观察和显微镜检查,但现在已不太常用。
● 如果血尿以第一杯为主,多为尿道出血, 如炎症、异物、结石、息肉或阴茎段尿道损伤;
● 排尿血尿以第三杯为主,或滴血常见于多为膀胱出血。
● 如果三杯均有血尿,多见于肾脏或输尿管出血。
4. 尿细菌学检查:
● 取清洁的中断尿,看看有没有尿路感染。
● 怀疑是尿路结核时,还要做涂片、染色,查找抗酸杆菌。
5. CT 扫描
6. B 超检查
7. 静脉肾盂造影(IVP)
8. 肾脏细胞学及组织学检查

做了检查之后,医生会根据病史、查体和辅助检查结果,综合分析判断[8]。


总而言之,出现血尿,不必慌张失措
一方面,合理休息,避免剧烈运动。
另一方面,如果血尿不能自己消失,积极就诊,由医生判断是暂时性血尿还是病理性血尿,并科学治疗。
审稿专家:候艳娇
山东大学齐鲁医院德州医院主管检验师一手配资开户网
广瑞网提示:文章来自网络,不代表本站观点。